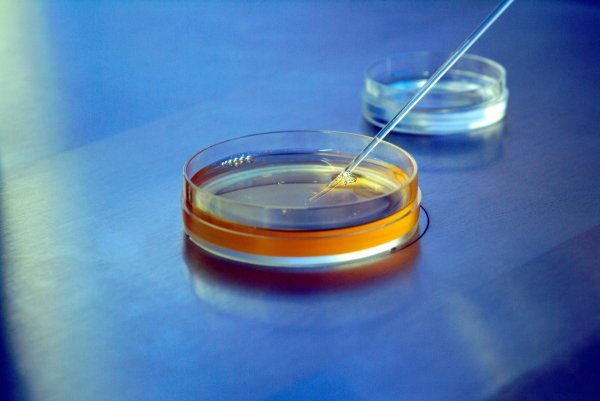
Neplodnost

Samo u Hrvatskoj 80.000 do 100.000 parova bori se s neplodnosti. Gledamo li udio u populaciji, slično je i u drugim zapadnim zemljama. Moderan način života kumovao je ovako crnoj statistici, no zahvaljujući napretku medicine, za mnoge parove postoji rješenje. O uzrocima neplodnosti, društvenoj stigmatizaciji, ali i potrebnoj demistifikaciji liječenja razgovarali smo s ginekologom Petrom Poljakom
Onima koji su gledali seriju 'Sluškinjina priča' ili čitali istoimeni roman vjerojatno se ledi krv u žilama pri pomisli na distopijski scenarij u kojem je neplodnost u svijetu postala toliki problem da je iznjedrila totalitaristički sustav u kojem fertilne žene postaju robinje za reprodukciju. Knedla u grlu još je veća jer smo svi svjesni toga da je neplodnost sve izraženiji problem današnjeg društva.
Uzroka je više, a svi se mogu povezati s modernim načinom života – odgađanje trudnoće, nezdrave prehrambene navike, manjak aktivnosti samo su neki od njih, a sve veći problem su i tzv. okolišni čimbenici poput zagađenosti zraka i rafinirane hrane.
Prema najnovijem izvješću Svjetske zdravstvene organizacije (WHO), svaki šesti par u svijetu suočava se s ovim problemom. I dok je dio društva odabrao život bez djece, oni koji ih ne mogu imati nerijetko se suočavaju s duševnom boli, ali i društvenom stigmatizacijom. No ono što zabrinjava je to da se prije samo 20-ak godina s ovim problemom suočavao svaki deseti par. Nastavi li se dakle krivulja rasta, procjenjuje se da bi do 2030. neplodnost mogla pogađati svaki treći par.
Samo deset posto ih se javi liječniku
Unatoč tome što za velik dio tih ljudi postoji rješenje – prije svega liječenje neplodnosti, a i medicinski potpomognuta oplodnja (MPO) – mnogi i dalje zaziru od alternative iz osobnih uvjerenja i/ili zbog društvene stigme, pa nikad ni ne potraže liječničku pomoć.
'Samo deset posto od 80.000 do 100.000 parova u Hrvatskoj koji se bore s neplodnosti potraži pomoć liječnika', upozorava dr. Petar Poljak, ginekolog iz splitske Poliklinike Cito, naglasivši da je nužno demistificirati liječenje neplodnosti i MPO-a, kao i destigmatizirati neplodnost u današnjem društvu kako bismo vidjeli veće pomake.
'Pacijenti su općenito slabo informirani o liječenju, za što oni, naravno, nisu krivi. Prisutan je strah i dovoljan je samo jedan razgovor da vide da to nije ništa strašno. Mnogi misle da će odmah završiti na MPO-u, a u većini slučajeva dovoljna je mala intervencija poput regulacije hormona', dodaje.
Liječenje neplodnosti nije sramota
Posljednjih godina se što se tiče društvene svijesti ipak vidi promjena na bolje, ali je i dalje izrazito važno ponavljati da nije nikakva sramota liječiti neplodnost, što u našem društvu katkad posebno teško pada muškarcima.
'Za trudnoću je potrebno dvoje. Znao sam imati muškarce koji su odbijali napraviti spermiogram (analiza sjemene tekućine) jer 'problem ne može nikako biti u njima'', kaže dr. Poljak, dodavši da je medicina na ovom polju toliko napredovala da urolozi - androlozi danas imaju znanje potrebno da se popravi spermiogram.
Ako u godinu dana nezaštićenih spolnih odnosa ne dođe do trudnoće, pa makar to bila neuspjela trudnoća, govorimo o neplodnosti. Ako je pak riječ o paru starijem od 35 godina, bilo bi dobro javiti se liječniku već nakon šest mjeseci. Poljak naglašava da je važno to da fokus više nije samo na ženama jer se posljednjih godina sve više muškaraca muči s ovim problemom.
'U 30-40 posto slučajeva neplodna je žena, a sve češće su to i muškarci, pa se njihov postotak danas izjednačio. U ostalim slučajevima neplodnost je idiopatska, gdje ne možemo pronaći uzrok', ističe.
Odgađanje prve trudnoće najveći problem
I dok su kod muškaraca tri glavna uzroka za neplodnost pušenje, alkohol i prekomjerna težina, jedan od glavnih čimbenika koji utječu na neplodnost žena je dob. I što više idemo prema zapadu, to je viša prosječna dob u kojoj žena prvi put rađa. Tako ona u Španjolskoj iznosi 31 godinu, u Bugarskoj je 27 godina, a u Rumunjskoj i Turskoj 26 godina.
U Hrvatskoj pak, prema podacima iz 2021., žene prvi put rađaju s 29, a prosjek je prije 20-ak godina bio 26 godina, kada je zapravo i vrhunac plodnosti žena.
'Taj trend vidljiv je više-manje u svim zemljama. Što smo stariji, kvaliteta jajnih stanica je lošija. Nakon 35. godine događa se nagli pad u njihovoj kvaliteti i onda opet nakon 40. godine. A tu su i drugi čimbenici, poput pušenja, prekomjerne tjelesne težine, manjka aktivnosti, koji mogu pridonijeti neplodnosti', ističe dr. Poljak. Mlađim osobama nerijetko su potrebne samo male promjene, no u starijoj dobi, unatoč medicini, imamo prirodne granice koje ne možemo savladati.
Pet posto djece u Hrvatskoj začeto IVF-om
Baza liječenja je anamneza. Prvo se trebaju prikupiti svi potrebni nalazi o reproduktivnom zdravlju žene, a za muškarce je dovoljan samo spermiogram. U toj prvoj fazi nužno je prikupiti i podatke o štetnim navikama, reproduktivnoj povijesti, menstrualnom ciklusu i eventualno patologijama koje bi mogle utjecati na plodnost.
Slijedi plan liječenja, a on u najvećem broju slučajeva podrazumijeva samo blaže intervencije. Onima kojima liječenje ne pomogne sugerira se jedna od metoda medicinski potpomognute oplodnje.
Pet posto djece rođene u Hrvatskoj začeto je in vitro fertilizacijom (IVF), jednom od metoda MPO-a, a otkako je prije 40 godina prvi put rođeno dijete začeto ovim postupkom, 40.000 njih u Hrvatskoj došlo je na svijet zahvaljujući ovom postupku medicinski potpomognute oplodnje. No mnogi ga zaobilaze zbog osobnih uvjerenja.
Potrebna promjena zakona
'Ako se pokaže da liječenje nije uspjelo ili da nije moguće, sugeriramo im jedan od postupaka MPO-a, ali ga ne namećemo. Iako se i tu vide promjene, jer posljednjih godina neki parovi, koji su prvotno odbijali MPO, nakon godinu dana promijene mišljenje. No nekad ta godina koju smo izgubili puno znači', objašnjava dr. Poljak.
Država financira MPO ženama do 42. godine, i to samo zato što se nakon te godine izrazito smanjuje plodnost. Dr. Poljak smatra da je zakon tu nužno mijenjati jer nema smisla da država ne pomaže starijim ženama samo zato što imaju manje šanse da zatrudne. Kako kaže, njegova najstarija pacijentica, koja je uspješno zatrudnjela, imala je 47 godina. Pored toga, ovaj ginekolog ne slaže se ni sa sadašnjom regulacijom zamrzavanja jajnih stanica.
'To isto treba hitno mijenjati. Zakon nam diktira da je zamrzavanje jajnih stanica dozvoljeno, ali kome? Samo pacijenticama s onkofertilitetom – dakle onima koje se liječe zračenjem, što može rezultirati neplodnošću. Postoje žene kojima je već s 30 godina ugrožena plodnost iz nekog drugog razloga, ali nama su tu vezane ruke i one svoje jajne stanice, nažalost, još uvijek ne mogu zamrznuti', upozorava doktor, dodavši da je u svim zapadnim zemljama to dozvoljeno zakonom.
'Cijelo društvo je potrebno da se podigne svijest o mogućnostima liječenja i alternativnim metodama oplodnje. Mi Hrvati smo jako dobri u liječenju neplodnosti i uspješnosti MPO-a. Imamo sve, i vrhunske liječnike i opremu, te u svijetu kotiramo u razini s najboljim kućama, tako da bi bila šteta ne iskoristiti to', zaključno će dr. Poljak.